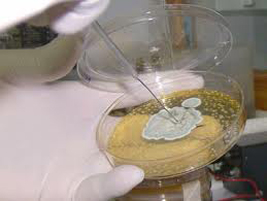

|
|
Dentro de la biología, podemos definir la micología como la ciencia que
se dedica al estudio de los hongos.
Aunque a nivel popular los hongos son asociados mayoritariamente con la
gastronomía estacional (setas, champiñones, etc.,) hay que decir que
esta clasificación vegetal representa una de las connotaciones menos
significativas de la micología, sin olvidar su papel en determinadas
enfermedades.
Dejando de lado la gastronomía estacional (micromicetos), y aunque
existen muchos tipos de hongos relacionados con enfermedades humanas,
tales como los Deuteromycetes, es necesario tener en cuenta que, en
general, los hongos son muy importantes en muchos procesos, tales como:
Fermentación de bebidas alcohólicas, maduración del queso o formación de
algunos tipos de pan, así como también para múltiples procesos
biotecnológicos, desarrollo de medicamentos, investigación
multidisciplinar, etc., de ahí su importancia para la vida
El conocimiento de los hongos, ha evolucionado profundamente en gran
parte debido a la evolución de la bioquímica.
Los hongos presentan una serie de características peculiares que hacen
que funcionen como eje de enlace de varias cadenas tróficas, presentando
características típicas de diferentes reinos (Animal, Vegetal y
Protista).
Son seres vivos heterotróficos (absorben sustancias orgánicas en
solución), sin clorofila y pueden tener un comportamiento saprobio,
parásito o simbiótico.
Se presentan formados por hifas, que se agrupan en un tejido no
verdadero (el micelio), excepción hecha a las levaduras, que son
unicelulares. Siendo delimitados exteriormente por una membrana rígida
conteniendo quitina y hemicelulosa, ellos se reproducen a enorme
velocidad mediante una enorme variedad de procesos sexuales, asexuales y
parasexuales.
Para estudiar el complejo mundo de la micología, se utilizan las cámaras
climáticas de laboratorio.
www.cci-calidad.com |